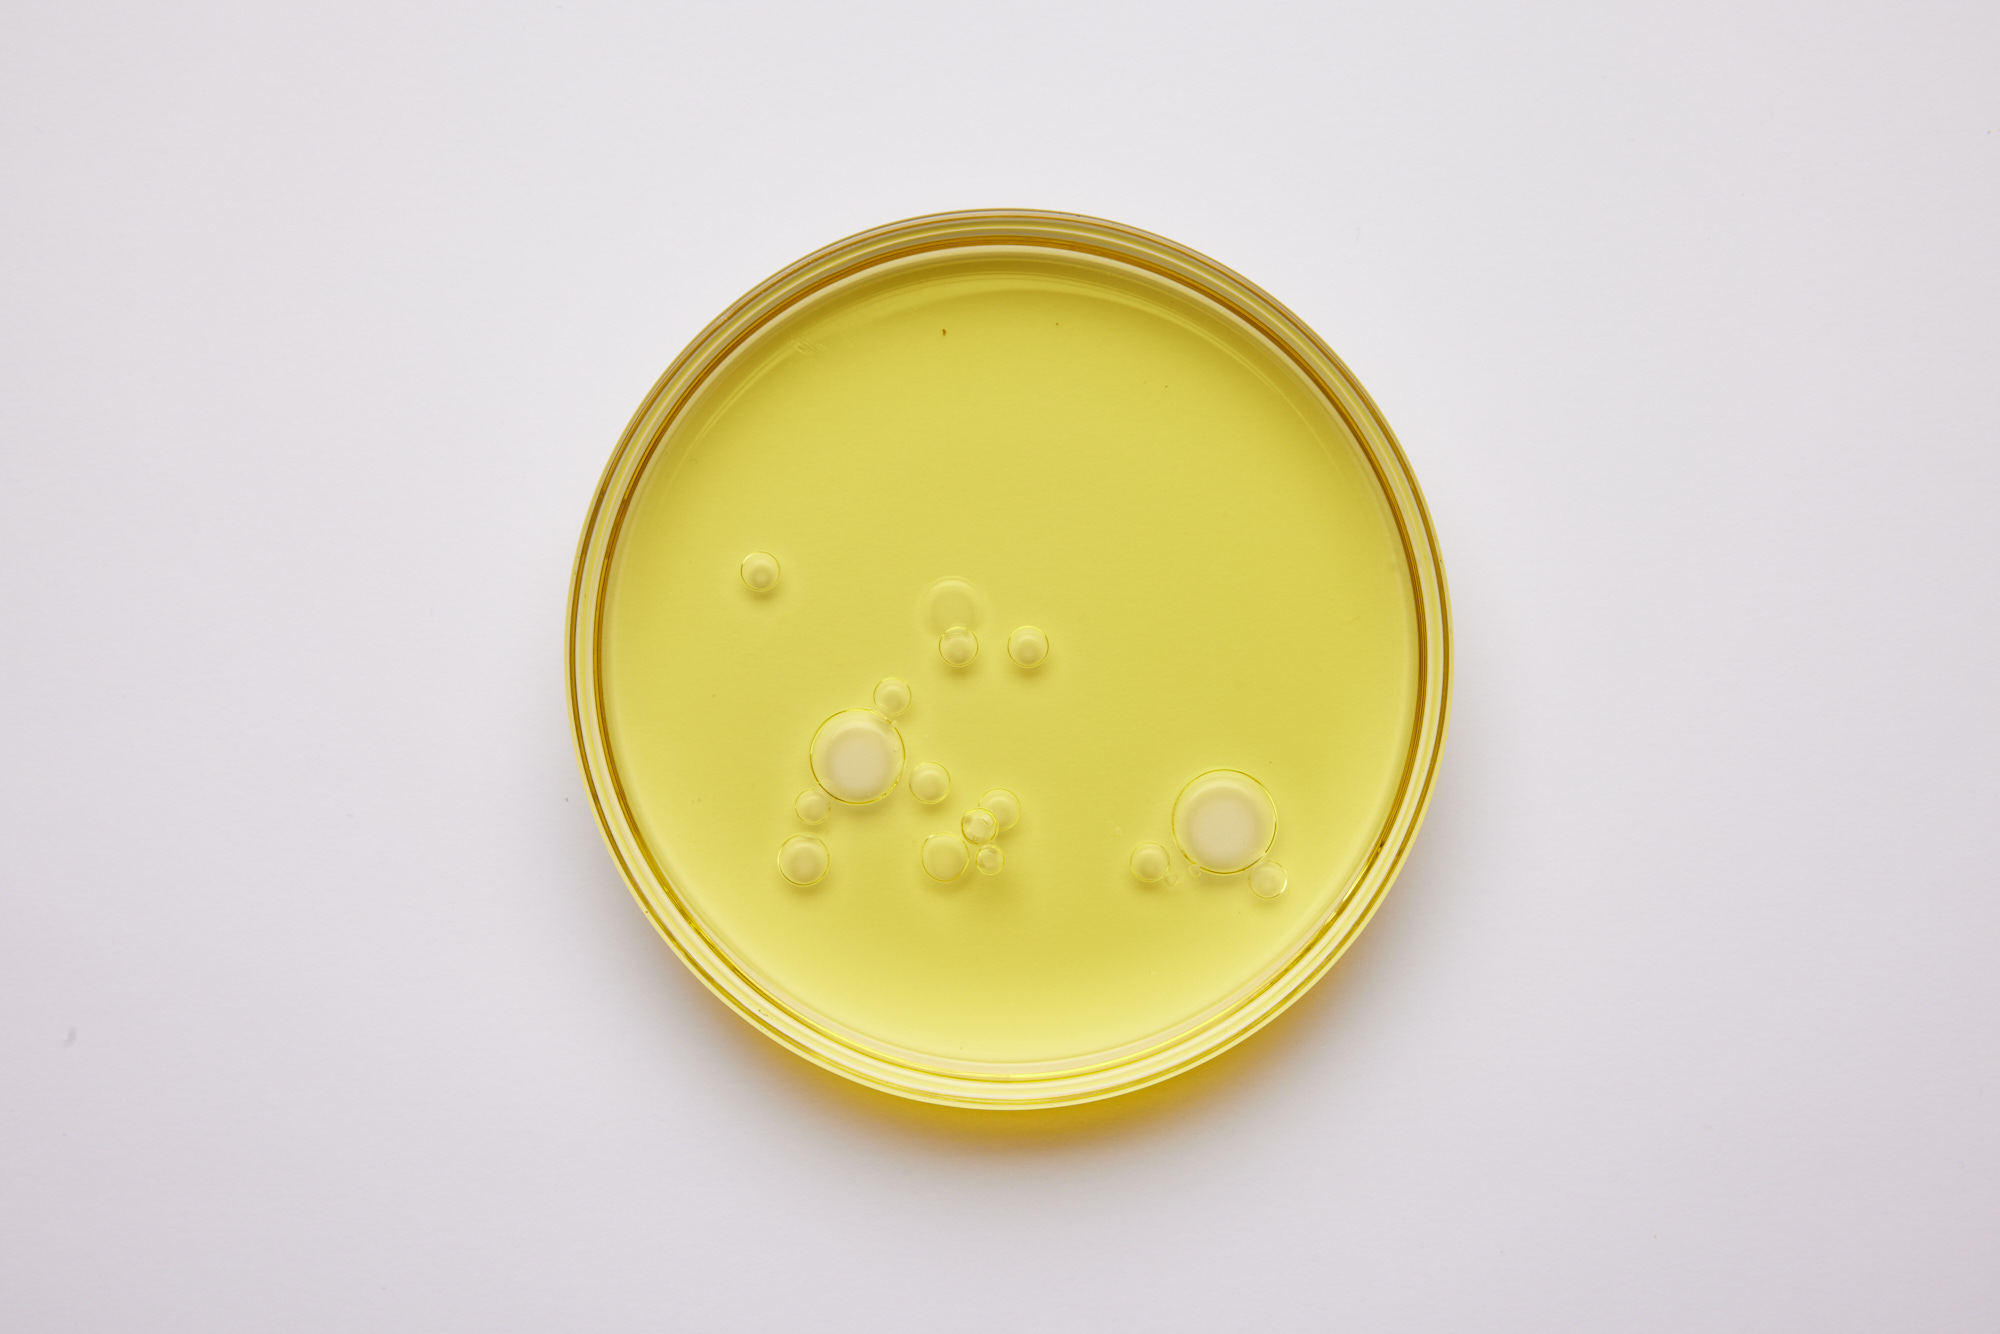
Volare

Oura
Bamla on älysormuksestaan tunnetun Ouran pitkäaikainen strateginen viestintätoimisto. Vastaamme yhtiön mediatyöstä Suomessa ja Pohjoismaissa. Yrityksen omien uutisten lisäksi ideoimme Ouralle jatkuvasti mielenkiintoisia, relevantteja ja kaupallisia tavoitteita edistäviä medialähtöjä.


Uber
Bamla on Uberin viestintä- ja PR-kumppani Suomessa. Suunnittelemme ja toteutamme yrityksen luovia PR-kampanjoita, ja varmistamme, että suomalaiset pysyvät ajan tasalla Uberin tuoreimmista yritysuutisista.



Bob W
Olemme majoitusalan kasvuyritys Bob W:n pitkäaikainen PR- ja viestintätoimisto. Tuemme Bob W:n tiimiä muun muassa strategisessa viestinnässä, johdon sparrauksessa, lanseerauksissa ja kiinnostavien mediatilaisuuksien järjestämisessä Suomessa ja ulkomailla. Pitkäjänteisen mediatyön tuloksena Bob W on saanut laadukasta medianäkyvyyttä useissa kotimaisissa ja kansainvälisissä medioissa, kuten Wall Street Journalissa, TechCrunchissa, Siftedissä, HS Visiossa, Kauppalehdessä ja Skiftissä.


Nebius
Bamla toimii maailman johtavan tekoälyinfrastruktuuria kehittävän teknologiayhtiö Nebiuksen strategisena viestintätoimistona Suomessa. Nebius on saanut merkittävät pääomasijoitukset NVDIAlta ja brittiläiseltä Accel-pääomasijoitusyhtiöltä.


Lifeline Ventures
Bamla ja pääomasijoitusyhtiö Lifeline Ventures ovat tehneet yhteistyötä yhtiön rahastojen lanseerauksissa. Viimeisimpänä Bamla tuki Lifelinen tiimiä uuden 400 miljoonan euron rahaston julkistuksessa, joka on Suomen kaikkien aikojen suurin VC-rahasto. Uutinen sai laajaa näkyvyyttä useissa suurissa kansainvälisissä ja kotimaisissa medioissa, kuten Bloombergissa ja Helsingin Sanomissa.



OpenOcean
Olemme pitkäaikainen PR- ja viestintätoimisto OpenOceanille, joka on yksi Euroopan menestyneimmistä pääomasijoittajista. Tuemme tiimiä kaikessa yrityksen viestinnässä aina dealflow-markkinoinnista rahastosijoittajaviestintään. Vastaamme myös yrityksen sisällöntuotannosta ja sosiaalisen median markkinoinnista, minkä lisäksi tuemme tapahtumien järjestämisessä ja muussa näkyvyydessä.



Nets
Olemme Euroopan johtavan maksupalveluyritys Netsin PR- ja viestintätoimisto. Työskentelemme tiiviisti Netsin Suomen ja muiden Pohjoismaiden tiimien kanssa rakentaen vahvaa näkyvyyttä yhtiön uutisille ja medialähdöille.



Sooma
Bamla on masennuksen hoitoon erikoistuneen terveysteknologiayritys Sooman strateginen viestintätoimisto. Yhteistyömme aikana Sooma on kasvattanut paikallista medianäkyvyyttään merkittävästi sekä tiivistänyt suhteitaan kotimaisiin ja kansainvälisiin toimittajiin.
.jpg)

Slush
Slush on maailman johtava startup- ja teknologiatapahtuma. Bamla on Slushin pitkäaikainen PR-kumppani ja tukee Slushin tiimiä kansainvälisissä mediasuhteissa ja strategisessa PR:ssä.

Verdane
Bamla ja rahastoyhtiö Verdane ovat tehneet yhteistyötä muun muassa yhtiön merkittävän miljardirahaston lanseerauksessa. Uutinen sai laajaa näkyvyyttä suomalaisessa talousmediassa.

Volare
Volare on suomalainen bioteknologiayritys, joka kehittää kestäviä ratkaisuja ruoantuotannon uudistamiseen. Volaren PR- ja viestintätoimistona toimimme niin strategisen viestinnän kuin sisällöntuotannon tukena. Yhteistyömme ansiosta Volare on kasvattanut medianäkyvyyttään sekä suomalaisissa että kansainvälisissä medioissa ja alakohtaisissa julkaisuissa.



Ruokaboksi
Toimimme kotimaisen ateriakassipalvelu Ruokaboksin strategisena PR- ja viestintätoimistona. Bamla suunnittelee ja toteuttaa Ruokaboksin PR-lähtöjä ja mediatilaisuuksia sekä tukee tiimiä mediasuhteissa.


Quanscient
Bamla toimi kvanttiteknologiayritys Quanscientin viestintätoimistona yrityksen rahoituskierroksen uutisoinnissa. Strategisen PR-työn avulla onnistuimme asemoimaan Quanscientin kvanttialgoritmien edelläkävijäksi ja saavuttamaan mediahuomioita sekä keskeisimmissä kotimaan medioissa että kansainvälisissä alakohtaisissa medioissa.


Innovestor
Bamla tukee sijoitusyhtiö Innovestoria strategisessa viestinnässä ja PR:ssä. Olemme auttaneet Innovestorin tiimiä uusien lähtöjen lanseerauksessa ja kiinnostavien mediatilaisuuksien järjestämisessä sekä toimineet johdon jatkuvana viestinnän tukena. Pitkäjänteisen yhteistyön tuloksena Innovestor on onnistunut kasvattamaan näkyvyyttään mediassa sekä kotimaassa että kansainvälisesti.


Impaktly
Bamla on toiminut konsulttiyhtiö Impaktlyn strategisena viestintätoimistona Nordic Business Diversity Indexin -raportin lanseerauksessa. Raportti tutkii monimuotoisuuden, tasa-arvon ja inklusiivisuuden toteutumista pohjoismaisissa pörssiyhtiöissä. Raportin lanseerauksen ympärille rakennetut mediaviestintäkampanjat ovat saavuttaneet vahvaa näkyvyyttä keskeisimmissä talousmedioissa Suomessa ja muissa Pohjoismaissa.

Business Finland
Bamla järjesti yhteistyössä Business Finlandin kanssa kansainvälisille toimittajille mediamatkan Suomeen ja Slushiin. Matka esitteli Suomen osaamista digitaaliseen turvallisuuden ja uusien teknologioiden ympärillä ja tutustutti toimittajat johtaviin suomalaisiin teknologiayrityksiin. Matkalle osallistui useita kansainvälisiä arvostettuja medioita, ja matkan jälkeen ne julkaisivat useita feature-artikkeleita suomalaisista teknologiayrityksistä.


Startup Foundation
Startup-säätiö on merkittävä toimija suomalaisessa startup-ekosysteemissä. Säätiö tukee aikaisen vaiheen yrittäjiä erilaisilla aloitteilla ja toimii Slushin, Junctionin ja Maria 01:sen taustatukena. Bamla on Startup-säätiön pitkäaikainen viestintätoimisto.


Alvar Pet
Bamla toimi lemmikkialan kasvuyritys Alvar Petin viestintätoimistona, kun yritys uutisoi kahdesta merkittävästä virstanpylväästä: yrityskaupasta sekä uudesta yhteistyöstään Juuri Partnersin, Suomen johtavan pääomasijoitusyhtiön, kanssa. Uutinen sai laajaa huomiota suomalaisessa ja kansainvälisessä mediassa.


Sevendos
Olemme strateginen viestintätoimisto Sevendokselle, joka on teknologiakonsultointiin erikoistunut kasvuyritys. Työskentelemme tiiviisti yrityksen johdon kanssa vahvistaaksemme heidän ajatusjohtajuuttaan ja näkyvyyttään mediassa.


Vendep Capital
Bamla tuki suomalaista pääomasijoitusyhtiö Vendep Capitalia yhtiön neljännen rahaston lanseerauksessa, joka keskittyy varhaisen vaiheen B2B SaaS-yrityksiin Pohjoismaissa ja Baltiassa. Strategisen mediatyön tuloksena Vendepin tarina keräsi laajaa näkyvyyttä niin pohjoismaisissa kuin kansainvälisissä medioissa.


Maria 01
Bamla toimii Maria 01:n Pohjoismaiden johtavan startupkeskittymän strategisena viestintä- ja PR-toimistona. Ideoimme Maria 01:lle jatkuvasti mielenkiintoisia medialähtöjä. Proaktiivisen PR-työn avulla Maria 01 on kasvattanut medianäkyvyyttään sekä kotimaisessa että kansinvälisessä mediassa.
.png)


Inven
Bamla teki yhteistyötä Invenin kanssa yrityksen viimeisimmän rahoituskierroksen uutisoinnissa. Inven on suomalainen teknologiayhtiö, joka kehittää tekoälyalustaa parhaiden yritysostokohteiden löytämiseen. Uutinen sai erinomaista medianäkyvyyttä muun muassa Talouselämässä ja Siftedissä sekä muissa kotimaisissa ja kansainvälisissä talousmedioissa eri puolilla Eurooppaa.
Ota yhteyttä
+358 41 545 8441